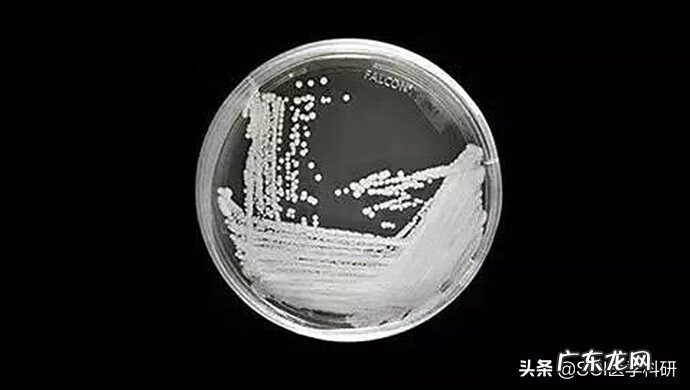
念珠菌长什么样图片 什么叫耳念珠菌

文章插图
需要注意的是,耳念珠菌通常不会影响没有任何健康问题的人 。前往其他国家或与患有耳念珠菌的亲人接触不应增加健康人的风险 。
但是,仍然必须保持良好的卫生习惯,以防止将感染传播给其他易受伤害的人 。
诊断耳念珠菌感染需要特定的实验室设备和测试 。许多设施无法使用这些工具,这可能会增加误诊的可能性并增加感染传播的风险 。
这CDC可信来源建议只要念珠菌留在人体内,就进行安全接触程序 。这是具有挑战性的,因为一些证据表明念珠菌可以定植一个人许多个月可信来源.
虽然护理设施中存在念珠菌爆发的风险,但这些护理设施可以通过多种方式来防止耳念珠菌的传播 。
有助于防止传播和爆发的安全做法包括:
筛查患者以确定风险和定植
限制与患有耳念珠菌的患者一起工作的人数
将患者留在单人间或与其他没有感染的患者分开
经常洗手
使用医院级消毒剂
与患者参加的其他护理机构沟通以跟进患者的状态
概括
耳念珠菌是一种可以传染给人类的真菌 。
感染通常发生在免疫系统受损、服用强效抗生素的人群中,或者经常或长时间去医院或其他护理机构的人群 。健康的人不太可能感染 。
C. auris感染可能很严重,甚至危及生命,因此治疗和预防至关重要 。
【念珠菌长什么样图片 什么叫耳念珠菌】护理机构必须迅速开展工作以筛查和测试患者的耳念珠菌,以开始治疗 。遵循 CDC 指南也有助于降低爆发的风险 。
- 手相看财运9个特征 什么样是有财运的手相
- 桃花的芽是什么芽 桃花的嫩芽长什么样
- 盲鱼是什么样子的 盲鱼好养吗
- 什么叫有魅力的男人 什么样的男人有魅力
- 什么样的行为是属于性骚扰
- 什么样面相的女人感情会不顺呢
- 坚果是什么样子果图片 坚果是什么样子
- 女生喜欢什么样的男生头像 女生喜欢什么样的男生
- 起诉离婚什么样的理由比较快
- 高情商的销售聊天应该是什么样子的
特别声明:本站内容均来自网友提供或互联网,仅供参考,请勿用于商业和其他非法用途。如果侵犯了您的权益请与我们联系,我们将在24小时内删除。
